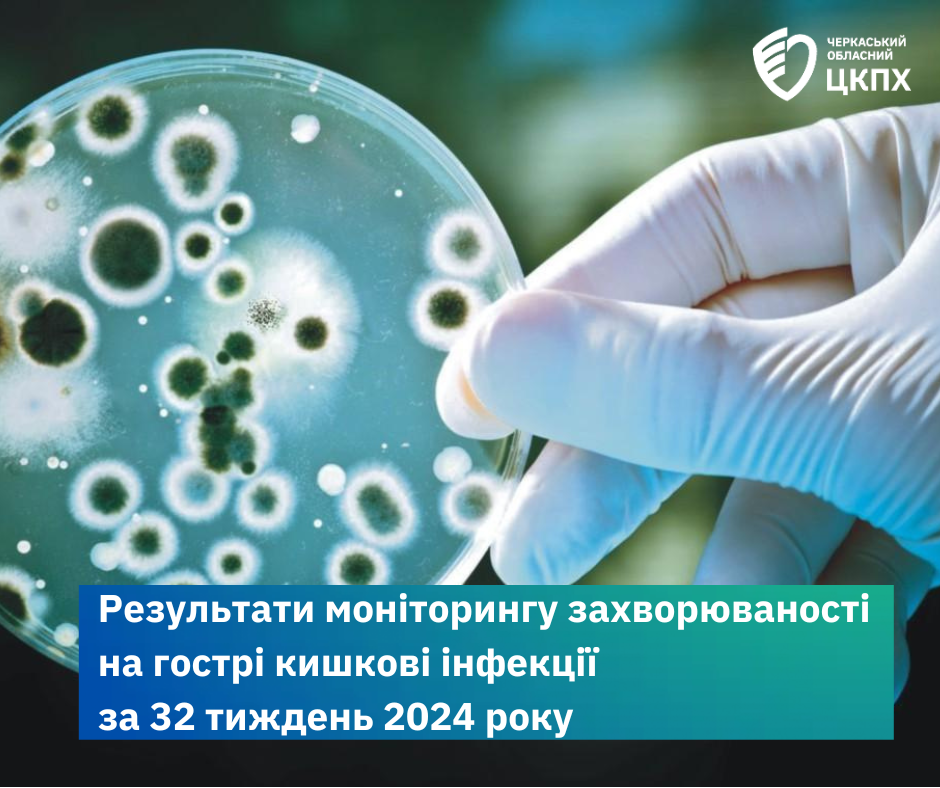

Результати моніторингу захворюваності на гострі кишкові інфекції за 32-й тиждень 2024 року
12 серпня 2024
За результатами щотижневого моніторингу інфекційної захворюваності на гострі кишкові інфекції з 3 по 9 серпня 2024 (32-й тиждень року), який проведено фахівцями Державної установи «Черкаський обласний центр контролю та профілактики хвороб МОЗ України», в області зареєстровано 53 випадки захворювань на гострі кишкові інфекції.
Інтенсивний показник на 100 тисяч населення – 4,58, що на 14,5 % менше, ніж за аналогічний період минулого року (62 випадки та 5,36 відповідно).
На територіях об’єднаних територіальних громад на гострі кишкові інфекції захворіли: у Черкаському районі – 26 осіб (інт. пок. – 4,48 на 100 тис. населення), Уманському – 16 осіб (6,47 на 100 тис. нас.), Звенигородському – 6 осіб (3,09 на 100 тис. нас.), Золотоніському – 5 (3,69 на 100 тис.нас.).
У структурі зареєстрованих ГКІ гастроентероколіти невстановленої етіології складали – 58,5%, гастроентероколіти встановленої етіології – 32,1%, сальмонельоз – 9,4%.
Спорадичні випадки сальмонельозу реєструвалися на територіях Новодмитрівської, Паланської, Ротмистрівської, Руськополянської та Смілянської міської територіальних громад.
В осередках інфекції проведені усі протиепідемічні та профілактичні заходи.
Щоб не захворіти на гострі кишкові інфекції, дотримуйтесь чистоти та гігієни навколо вас:
- завжди мийте руки перед вживанням та приготуванням їжі, після перебування у місцях масового скупчення людей (вулиці, ринки, пляжі, магазини, транспорт, відпочинок на природі), після відвідування туалету;
- не торкайтесь обличчя невимитими руками;
- вживайте воду гарантованої якості;
- купаючись у водоймі, не ковтайте воду;
- перед вживанням ретельно мийте питною водою овочі та фрукти.
УВАГА!
При появі симптомів захворювання – підвищення температури тіла, головний біль, блювання, рідкі випорожнення, біль у животі тощо, своєчасно звертайтесь за медичною допомогою.
Самолікування може призвести до значних ускладнень. Особливо це стосується дітей раннього віку.
Тож дбайте про своє здоров’я та не хворійте!




